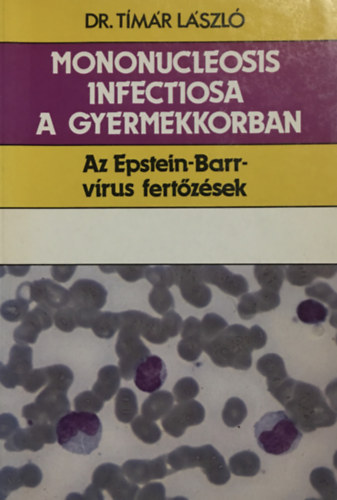

Könyvek
KategóriákE-könyvek
KategóriákAntikvár
Kategóriák- ElőrendelhetőKategóriák
Sikerlista
KategóriákÚjdonságok
Kategóriák- Belépés/regisztráció
Törzsvásárlói pontegyenleg:
Törzsvásárló kártyám
Kedvezmény mértéke:
Törzsvásárló kártyám
Legyen ön is Libri
Törzsvásárlói kártya igénylés vagy meglévő kártya fiókhoz rögzítése
Törzsvásárló!
- Kilépés
- KönyvekKategóriák
- E-könyvekKategóriák
- HangoskönyvekKategóriák
- AntikvárKategóriák
- Zene, film, ajándék
- Akciók
- ElőrendelhetőKategóriák
- SikerlistaKategóriák szerint
- ÚjdonságokKategóriák
- Információk